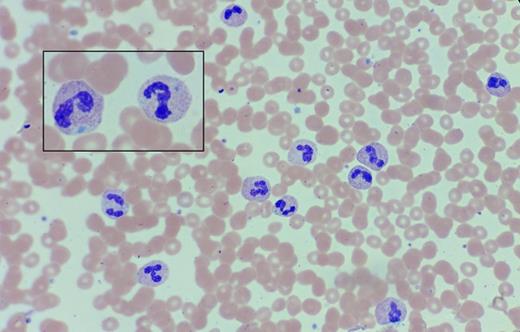
Peripheral Blood Smear. Peripheral blood smear in a 68-year-old woman with a history of chronic leukocytosis.

A 68-year-old woman with a history of chronic leukocytosis was referred for a second opinion. She has no significant past medical history. She has smoked a pack of cigarettes weekly for the past 30 years. She initially presented with a mild neutrophilic leukocytosis, which has been slowly progressive throughout the past 17 years (WBC 13.3-32.7 × 109/L; absolute neutrophil count 26.5 × 109/L at the time of referral). The hemoglobin and platelet count are normal. She has remained asymptomatic during this period and does not have palpable lymphadenopathy or hepatosplenomegaly on examination. A peripheral blood smear is shown below.
Peripheral Blood Smear. Peripheral blood smear in a 68-year-old woman with a history of chronic leukocytosis.
Peripheral Blood Smear. Peripheral blood smear in a 68-year-old woman with a history of chronic leukocytosis.
A. Atypical chronic myeloid leukemia
B. Leukemoid reaction
C. Cigarette smoking
D. Chronic neutrophilic leukemia
Sorry, that was not the preferred response.
Correct!
The neutrophils exhibit toxic granulation, with some cells containing basophilic Döhle bodies in the cytoplasm (inset). Prior testing was negative for BCR-ABL1. At the time of consultation, myeloid mutation panel testing revealed CSF3R T618I, a somatic activating mutation of the G-CSF receptor. The smear findings of neutrophil toxic granulation and Döhle bodies, as well as the identification of the CSF3R T618I mutation are consistent with a diagnosis of chronic neutrophilic leukemia (CNL).1-4 Atypical CML (aCML) is distinguished from CNL by the presence of increased myeloid precursors (promyelocytes, myelocytes, metamyelocytes) comprising >10 percent of leukocytes in the peripheral blood, as well as prominent dysgranulopoiesis (e.g. abnormal chromatin clumping) with or without dysplasia in the erythroid and megakaryocytic lineages.1 The lack of myeloid immaturity and dysplasia on the peripheral blood smear, as well as the finding of the CSF3R T618I mutation (rare in atypical CML) favors the diagnosis of CNL over aCML. The oncogenic CSF3R T618I mutation results in dysregulated JAK2 V617F signaling, which can be targeted by JAK inhibition, a therapeutic paradigm currently being evaluated in a multicenter trial. This patient's CNL is notable for the unusually long history of leukocytosis; this is in marked contradistinction to literature reports that generally cite a median overall survival of less than two years, with 20 percent experiencing transformation to blast phase at a median of 21 months from the time of diagnosis. The most common causes of death in reported series of CNL include progressive disease, leukemic transformation, intracranial hemorrhage, and treatment-related toxicity or infection.3-4
A leukemoid reaction (which generally has been used to denote a leukocytosis > 50 × 109/L) is characterized by a left-shifted neutrophilia with a range of myeloid precursors on the peripheral blood smear. “Leukemoid reaction” is a nonspecific term generally used to describe a response to a wide variety of triggers, including infection, inflammation, medications (e.g., myeloid growth factors), hemorrhage, splenectomy, and organ ischemia/necrosis. However, most leukemoid reactions would not be expected to produce a sustained leukocytosis as is observed in this case. Cigarette smoking can also produce a modest myeloid/neutrophilic leukocytosis due to a chronic inflammatory state causing demargination of mature neutrophils from the vascular endothelium; however, the magnitude of neutrophilia and toxic granulation found in this case are not consistent with this diagnosis.
References
References
Dr. Gotlib is a principal investigator on a trial of the JAK1/JAK2 inhibitor ruxolitinib in patients with CNL and atypical CML. He has received research funding and honoraria from Incyte, Inc., manufacturer of ruxolitinib, and sponsor of the trial.